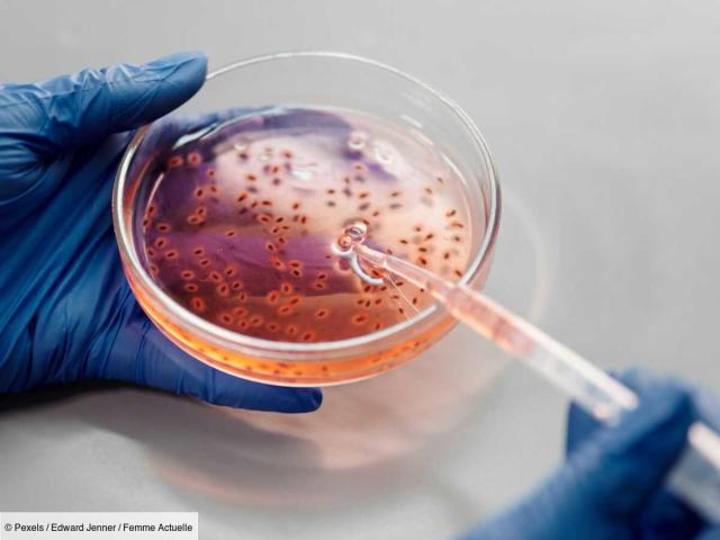

Africa-Press – Gabon. L’Agence européenne des médicaments (EMA) a approuvé l’utilisation d’un vaccin contre la variole humaine, l’Imvanex, pour étendre son utilisation à des adultes afin de lutter contre la propagation inquiétante de la variole du singe.
Ce vaccin de la société danoise Bavarian Nordic est approuvé dans l’UE depuis 2013 pour la prévention de la variole. Il a été approuvé également contre la variole du singe vendredi en raison de la similitude avec le virus de la variole.
Directeur de l’OMS « inquiet »
Le directeur général de l’OMS, Tedros Adhanom Ghebreyesus, s’est dit « inquiet » jeudi de l’augmentation du nombre de cas de variole du singe lors de l’ouverture d’une réunion du Comité d’urgence, demandant conseil aux experts. C’est à lui qu’incombe la responsabilité d’éventuellement déclarer l’urgence de santé publique de portée internationale, le plus haut degré d’alerte de l’agence de santé.
La situation s’est aggravée ces dernières semaines avec désormais plus de 15’300 cas recensés dans 71 pays, selon les derniers chiffres des autorités sanitaires des Etats-Unis (CDC), les plus à jour. Lors d’une première réunion le 23 juin, la majorité des experts avaient recommandé à l’OMS et au Dr Tedros de ne pas prononcer l’urgence de santé publique de portée internationale.
Moins dangereux et contagieux que la variole
Décelée pour la première fois chez l’humain en 1970, la variole du singe est moins dangereuse et contagieuse que sa cousine la variole, éradiquée en 1980. La maladie se traduit d’abord par une forte fièvre et évolue rapidement en éruption cutanée. Le plus souvent bénigne, elle guérit généralement spontanément après deux à trois semaines.
Pour plus d’informations et d’analyses sur la Gabon, suivez Africa-Press